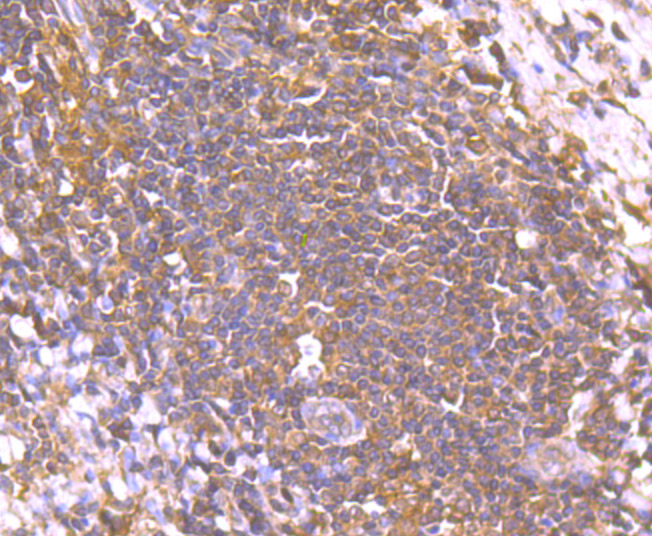
EM1701-44_6.jpg

Smad2 Mouse Monoclonal Antibody [C9-B0]

cat.: EM1701-44
| Product Type: | Mouse monoclonal IgG1, primary antibodies |
|---|---|
| Species reactivity: | Human, Mouse, Rat |
| Applications: | WB, IHC-P, IF-Cell |
| Clonality: | Monoclonal |
| Clone number: | C9-B0 |
| Form: | Liquid |
| Storage condition: | Store at +4℃ after thawing. Aliquot store at -20℃ or -80℃. Avoid repeated freeze / thaw cycles. |
| Storage buffer: | 1*PBS (pH7.4), 0.2% BSA, 50% Glycerol. Preservative: 0.05% Sodium Azide. |
| Concentration: | 2ug/ul |
| Purification: | Protein G affinity purified. |
| Molecular weight: | 58 kDa |
| Isotype: | IgG1 |
| Immunogen: | Recombinant protein within Human Smad2 aa 151-450 / 467. |
| Positive control: | Hela, A549, HUVEC, rat testis tissue, human tonsil tissue, human liver cancer tissue, mouse brain tissue. |
| Subcellular location: | Cytoplasm. Nucleus. |
| Recommended Dilutions:
WB IF-Cell IHC-P |
1:500 1:50-1:200 1:50-1:200 |
| Uniprot #: | SwissProt: Q15796 Human | Q62432 Mouse | O70436 Rat |
| Alternative names: | Drosophila, homolog of, MADR2 hMAD-2 HsMAD2 JV18 JV18-1 JV181 MAD MAD homolog 2 MAD Related Protein 2 Mad-related protein 2 MADH2 MADR2 MGC22139 MGC34440 Mother against DPP homolog 2 Mothers against decapentaplegic homolog 2 Mothers against decapentaplegic, Drosophila, homolog of, 2 Mothers against DPP homolog 2 OTTHUMP00000163489 Sma and Mad related protein 2 Sma- and Mad-related protein 2 MAD SMAD 2 SMAD family member 2 SMAD, mothers against DPP homolog 2 SMAD2 SMAD2_HUMAN |
Images

|
Fig1: Western blot analysis of Smad2 on Hela cell lysate using anti-Smad2 antibody at 1/500 dilution. |

|
Fig2: ICC staining Smad2 (green) in HUVEC cells. The nuclear counter stain is DAPI (blue). Cells were fixed in paraformaldehyde, permeabilised with 0.25% Triton X100/PBS. |

|
Fig3: ICC staining Smad2 (green) in A549 cells. The nuclear counter stain is DAPI (blue). Cells were fixed in paraformaldehyde, permeabilised with 0.25% Triton X100/PBS. |

|
Fig4: ICC staining Smad2 (green) in Hela cells. The nuclear counter stain is DAPI (blue). Cells were fixed in paraformaldehyde, permeabilised with 0.25% Triton X100/PBS. |

|
Fig5: Immunohistochemical analysis of paraffin-embedded mouse brain tissue using anti-Smad2 antibody. Counter stained with hematoxylin. |
|
Fig6: Immunohistochemical analysis of paraffin-embedded human tonsil tissue using anti-Smad2 antibody. Counter stained with hematoxylin. |

|
Fig7: Immunohistochemical analysis of paraffin-embedded human liver cancer tissue using anti-Smad2 antibody. Counter stained with hematoxylin. |
Note: All products are “FOR RESEARCH USE ONLY AND ARE NOT INTENDED FOR DIAGNOSTIC OR THERAPEUTIC USE”.